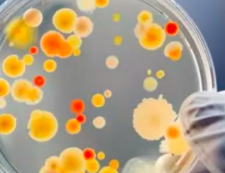

快速理解低功耗广域网TurMassTM与LoRa的五大技术对比
物联网的本质是物体状态信息的感知、传输、应用和控制。信息具有价值,获取需要成本,信息获取成本的降低和价值的上升是物联网发展的核心驱动力。物联网应用领域的不断发展使得对于低带宽低功耗的远距离传输应用需求不断增长,此类应用场景占到物联网连接总量的60%。为了解决目前技术存在终端功耗高、无法适应海量设备连接、广域覆盖能力不足和成本较高等问题,低功耗广域网络(Low Power Wide Area Network, LPWAN)技术成为了物联网发展浪潮中新的创新焦点。
- 2021-04-16
- 阅读1002
- 下载0
- 10页
- docx